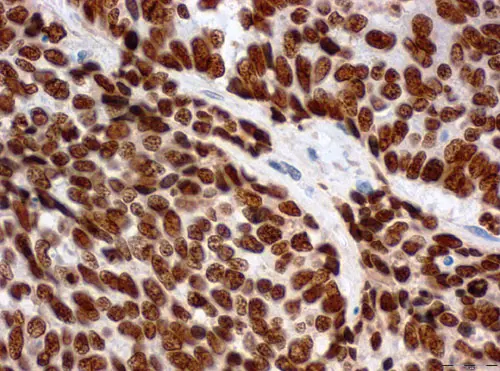
Querschnitt durch eine Gewebeprobe eines Gebärmutterhalstumors. Die Krebszellen enthalten hohe Mengen an LEDGF-Protein (braune Färbung).

Chemotherapeutika und Bestrahlungen schädigen die DNA von Krebszellen. Dadurch wird der sogenannte programmierte Zelltod aktiviert und die Tumorzellen sterben ab. Humane Papillomviren, die sich in Zellen des Gebärmutterhalses eingenistet haben, schützen ihre Wirtszellen vor diesem Schicksal und steigern damit ihre Resistenz gegen Krebstherapien. Wissenschaftler vermuteten schon seit Langem, dass die beiden viruseigenen Gene E6 und E7 an diesem Prozess beteiligt sind.
„Um herauszufinden, wie HPV ihre Wirtszellen vor DNA-Schäden schützen, haben wir die beiden Gene E6 und E7 in HPV-positiven Tumorzellen blockiert“, erklärt Jenny Leitz, die Erstautorin der Studie. Das Ergebnis: Ein Protein namens LEDGF, das Krebszellen vor DNA-Schäden schützen kann, wird ohne E6 und E7 kaum noch produziert.
Doch können die beiden HPV-Gene die Produktion von LEDGF auch aktivieren? Um diese Frage zu klären, schleusten die Forscher eines der beiden oder beide Virusgene in menschliche Hautzellen ein. „Tatsächlich hat sich die Menge an LEDGF in diesen Zellen deutlich erhöht“, sagt Jenny Leitz. „Dabei war der Effekt am stärksten, wenn wir beide Gene in die Zellen eingebracht haben.“
Auch in Gewebeschnitten von HPV-positiven Gebärmutterhalstumoren und deren Vorstufen fanden die Forscher höhere LEDGF-Konzentrationen als in gesundem Gewebe. Aber heißt das auch, dass hohe LEDGF-Konzentrationen tatsächlich vor DNA-Schäden schützen? Dafür behandelten die Wissenschaftler HPV-positive Gebärmutterhalskrebszellen mit DNA-schädigenden Chemikalien oder Gammastrahlen. „Wenn wir in den Krebszellen LEDGF blockiert haben, entstanden deutlich mehr DNA-Schäden und die Zellen teilten sich weniger“, berichtet Studienleiter Professor Felix Hoppe-Seyler. „Aus diesen Versuchen schließen wir, dass HPV die Produktion von LEDGF mithilfe ihrer Gene E6 und E7 aktivieren und Krebszellen so vor DNA-Schäden bewahren.“
Diese Erkenntnis könnte in Zukunft möglicherweise dazu genutzt werden, die Wirksamkeit von Chemo- und Strahlentherapie bei Tumoren zu steigern. „Dazu müsste es gelingen, LEDGF-Blocker zu entwickeln, die gezielt in Krebszellen wirken“, sagt Felix Hoppe-Seyler. „Doch bis dahin ist es noch ein weiter Weg.“
Die „Peter und Traudl Engelhorn-Stiftung“ fördert die Erstautorin Jenny Leitz mit einem Promotionsstipendium.
Leitz J, Reuschenbach M, Lohrey C, Honegger A, Accardi R, Tommasino M, Llano M, von Knebel Doeberitz M, Hoppe-Seyler K, Hoppe-Seyler F. (2014). Oncogenic Human Papillomaviruses Activate the Tumor-Associated Lens Epithelial-Derived Growth Factor (LEDGF) Gene. PLoS Pathog. doi: 10.1371/journal.ppat.1003957
Ein Bild zur Pressemitteilung steht im Internet zur Verfügung unter:
gebaermutterhalstumor.jpg
Bildunterschrift: Querschnitt durch eine Gewebeprobe eines Gebärmutterhalstumors. Die Krebszellen enthalten hohe Mengen an LEDGF-Protein (braune Färbung).
Quelle: Miriam Reuschenbach, Universitätsklinikum Heidelberg